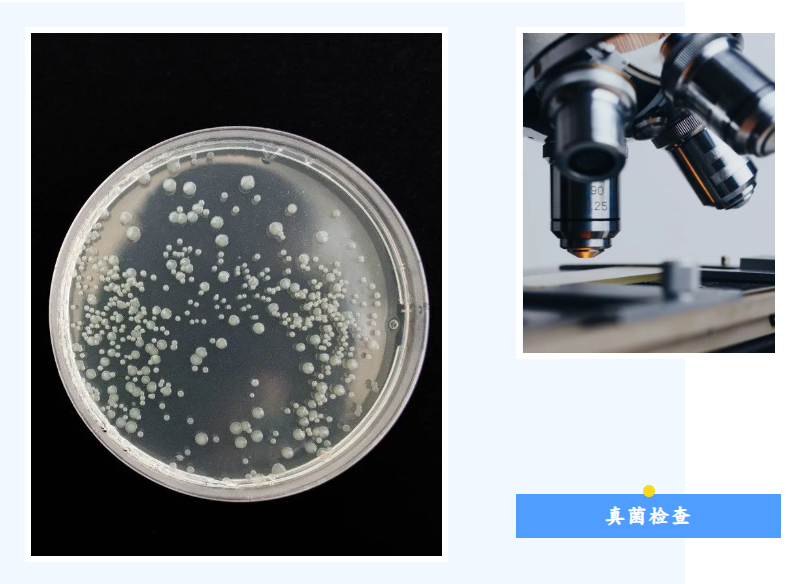
当皮肤遇上真菌感染，怎么检查？

当皮肤遇上真菌感染,怎么检查?
990 人阅读发布时间:2023-09-15 14:31

皮肤覆盖我们全身表面,是人体最大的器官,同时和粘膜组成了人体第一道免疫防线。
然而近年来随着人们生活节奏加快、大气污染严重,我国皮肤病病发率不断提高。仅皮肤浅部真菌病的发病率在我国可达20%-25%,且有逐年增加的趋势。
真菌性皮肤病是皮肤病中较为常见的一类,是由真菌引起的人类皮肤、黏膜及毛/发和甲等皮肤附属器的浅部感染性疾病,具有发病率高、有传染性、易复发或再感染的特点。常见的真菌性皮肤病有头癣、手足癣、股癣、花斑癣等。
临床上,真菌性皮肤病可以通过真菌显微镜检测、真菌培养、伍德灯检查等方法检测,确认患者真菌感染以及阳性率。
例如在《中国甲真菌病诊疗指南(2021年版)》中提到,甲真菌病的病原学检查主要包括真菌镜检、真菌培养和组织病理检查,辅以分子生物学检测。
其中,作为真菌检测最简单也是最有用的一步——真菌镜检的方法有:使用10%-20% Potassium Hydroxide溶液处理刮取的甲屑进行制片,然后送去镜检;或使用荧光染色法辨认真菌菌丝和孢子。
当真菌镜检出现可疑酵母菌或其他霉菌的形态表现时,进一步做真菌培养或病理检查,从而综合判断出是否为致病菌。
今天要带大家认识的Potassium Hydroxide就是真菌镜检中常用的试剂,也可以用来快速鉴定革兰阴性菌与易脱色的革兰阳性菌。(真菌Potassium Hydroxide拉丝法:革兰阴性菌浸泡KOH溶液后,菌悬液呈现粘性可拉丝,而革兰阳性细菌无该变化)
Potassium Hydroxide主要用作化工原料,制备钾皂以及各种钾盐如potassium permanganate、山梨酸钾、柠檬酸钾、磷酸二氢钾等。Potassium Hydroxide还用于医药、轻工、印染、电镀、照相等行业作干燥剂、pH调节剂、原料等。
在医药领域,Potassium Hydroxide可以用来合成药物或药物中间体(如枸橼酸托法替布、硝酸奥昔康唑、苯磺酸贝他斯汀等);也能用来调节制剂的pH值;还可作为腐蚀剂,配制成5-10%溶液或软膏,用来治疗鸡眼、胼胝、赘疣等。
德国CG公司医药级Potassium Hydroxide,在完全遵守GMP条件下生产,符合Ph.Eur.、USP标准,可配合欧美申报。其生产过程严格把关,低杂质、高品质。
CG公司所有产品皆可提供第三方审计报告,这将对您的质量管理系统的完整性有更好的支持!
如有需要,欢迎前来咨询!
参考文献:
1、百度百科
2、《防治观念待提高,皮肤病发病率逐年走高》,界面新闻
3、《中国甲真菌病诊疗指南(2021年版)》
4、《化工助剂》,温辉梁主编
5、《中国钾盐工业概览》,魏成广等编
6、《皮肤科外用药物手册》,赵天恩,马世尧编
7、CN113209032A,《一种注射用门冬氨酸钾镁冻干粉针剂及其制备方法,用于治疗低钾血症、心律失常、心肌炎后遗症等疾病》,符永红,林方育,肖汉文,林小雪,唐雄肇;海南通用康力制药有限公司。
8、CN113577125A,《一种具有抗炎作用的五味甘露软膏剂及其制备方法》,邱丽颖,侯豹,戚梦婷,蔡维维,张建峰,宗咏花,朱雪锐,于晓依,班雅婷,胡江涛,康心勉;西藏藏医药大学,江南大学。